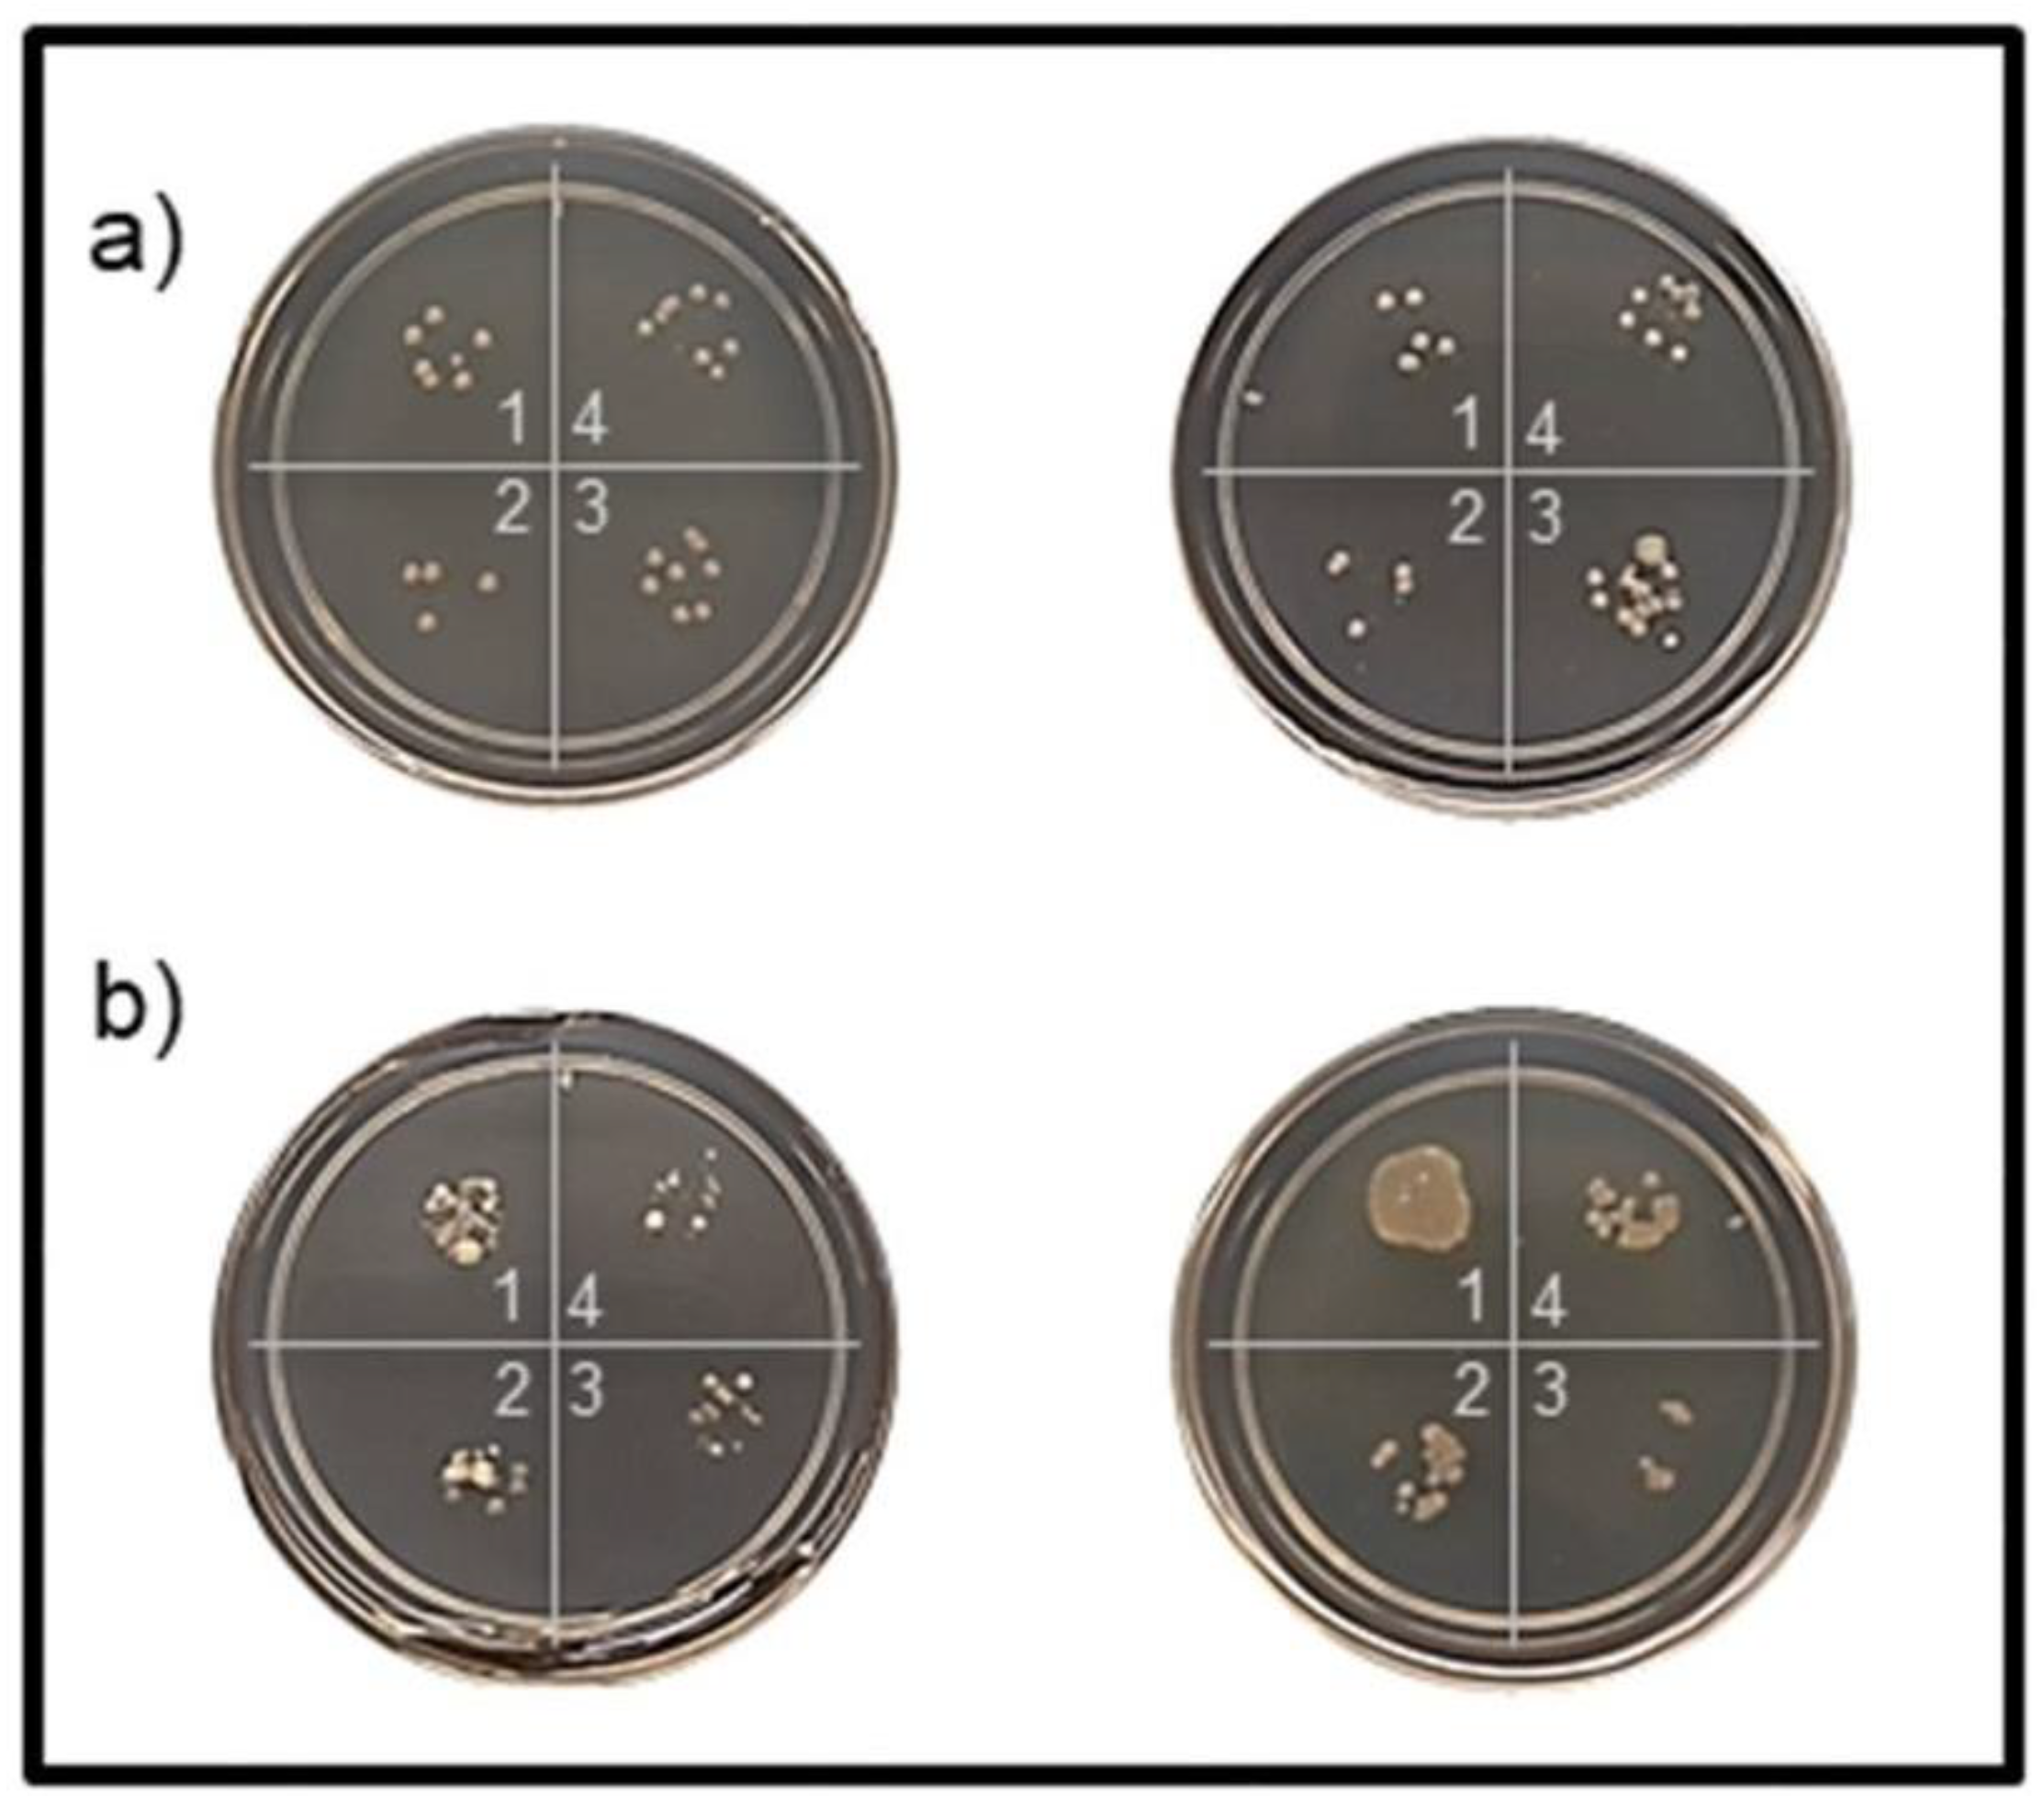
Jmse 09 00943 g008

Magnetically Recoverable and Reusable Titanium Dioxide Nanocomposite for Water Disinfection
Abstract
:1. Introduction
2. Materials and Methods
2.1. Chemicals
2.2. Synthesis of Fe3O4@SiO2 (MS)
2.3. Synthesis of Fe3O4@SiO2@TiO2
2.4. Material Characterization
2.5. Antimicrobial Experiments
2.5.1. Shaking Tests
2.5.2. Reusability Tests
2.5.3. Disinfection of Long Island Sound (LIS) Surface Water
3. Results and Discussion
3.1. Characterization
3.2. Antimicrobial Experiments
3.2.1. Shaking Tests
3.2.2. Reusability Tests
3.2.3. Disinfection of Long Island Sound (LIS) Surface Water
4. Conclusions
Author Contributions
Funding
Institutional Review Board Statement
Informed Consent Statement
Data Availability Statement
Acknowledgments
Conflicts of Interest
References
- International Maritime Organization (IMO). Ballast Water Management. Available online: https://www.imo.org/en/OurWork/Environment/Pages/BallastWaterManagement.aspx (accessed on 26 August 2021).
- Seiden, J.; Way, C.; Rivkin, R. Microbial hitchhikers: Dynamics of bacterial populations in ballast water during a trans-Pacific voyage of a bulk carrier. Aquat. Invasions 2010, 5, 13–22. [Google Scholar] [CrossRef]
- First, M.; Drake, L. Approaches for determining the effects of UV radiation on microorganisms in ballast water. Manag. Biol. Invasions 2013, 4, 87–99. [Google Scholar] [CrossRef] [Green Version]
- Moreno-Andrés, J.; Romero-Martínez, L.; Acevedo-Merino, A.; Nebot, E. UV-based technologies for marine water disinfection and the application to ballast water: Does salinity interfere with disinfection processes? Sci. Total Environ. 2017, 581–582, 144–152. [Google Scholar] [CrossRef]
- Saeed, S.; Prakash, S.; Deb, N.; Campbell, R.; Kolluru, V.; Febbo, E.; Dupont, J. Development of a site-specific kinetic model for chlorine decay and the formation of chlorination by-products in seawater. J. Mar. Sci. Eng. 2015, 3, 772–792. [Google Scholar] [CrossRef] [Green Version]
- Jing, L.; Chen, B.; Zhang, B.; Peng, H. A hybrid fuzzy stochastic analytical hierarchy process (FSAHP) approach for evaluating ballast water treatment technologies. Environ. Syst. Res. 2013, 2, 10. [Google Scholar] [CrossRef] [Green Version]
- Huang, W.; Chen, X.; Fan, Y.; Li, Y. Management of contaminated drinking water source in rural communities under climate change. J. Environ. Inform. 2020. Available online: http://www.jeionline.org/index.php?journal=mys&page=article&op=view&path%5B%5D=202000431 (accessed on 26 August 2021). [CrossRef]
- Krasner, S.W.; Weinberg, H.S.; Richardson, S.D.; Pastor, S.J.; Chinn, R.; Sclimenti, M.J.; Onstad, G.D.; Thruston, A.D. Occurrence of a new generation of disinfection byproducts. Environ. Sci. Technol. 2006, 40, 7175–7185. [Google Scholar] [CrossRef]
- Centers for Disease Control and Prevention. The safe water system—disinfection byproducts. Available online: www.cdc.gov/safewater/chlorination-byproducts.html (accessed on 26 August 2021).
- Shannon, M.A.; Bohn, P.W.; Elimelech, M.; Georgiadis, J.G.; Mariñas, B.J.; Mayes, A.M. Science and technology for water purification in the coming decades. Nature 2008, 452, 301–310. [Google Scholar] [CrossRef]
- Furlan, P.Y.; Fisher, A.J.; Furlan, A.Y.; Melcer, M.E.; Shinn, D.W.; Warren, J.B. Magnetically recoverable and reusable antimicrobial nanocomposite based on activated carbon, magnetite nanoparticles, and silver nanoparticles for water disinfection. Inventions 2017, 2, 10. [Google Scholar] [CrossRef] [Green Version]
- Furlan, P.Y.; Fisher, A.J.; Melcer, M.E.; Furlan, A.Y.; Warren, J.B. Preparing and testing a magnetic antimicrobial silver nanocomposite for water disinfection to gain experience at the nanochemistry–microbiology interface. J. Chem. Educ. 2017, 94, 488–493. [Google Scholar] [CrossRef]
- Furlan, P.Y.; Furlan, A.Y.; Melcer, M.E.; Shinn, D.W.; Warren, J.B. Facile Preparation of oxidation resistant magnetite-based nanocomposites for water treatment. In Proceedings of the 17th International Conference on Emerging Trends in Materials Science and Nanotechnology, Rome, Italy, 26–27 April 2018. Available online: https://www.imedpub.com/proceedings/facile-preparation-of-oxidation-resistant-magnetitebased-nanocomposites-for-water-treatments-2156.html (accessed on 26 August 2021).
- Furlan, P.Y.; Melcer, M.E. Removal of aromatic pollutant surrogate from water by recyclable magnetite-activated carbon nanocomposite: An experiment for general chemistry. J. Chem. Educ. 2014, 91, 1966–1970. [Google Scholar] [CrossRef]
- Furlan, P.Y.; Ackerman, B.M.; Melcer, M.E.; Perez, S.E. Reusable magnetic nanocomposite sponges for removing oil from water discharges. J. Ship Prod. Des. 2017, 33, 227–236. [Google Scholar] [CrossRef]
- Fisher, A.J.; Keeley, M.M.; Lane, J.M.; Furlan, P.Y. Spectroscopic evaluation of removal efficiency for a pharmaceutical pollutant in water using a magnetite-activated carbon nanocomposite. J. Chem. Educ. 2019, 96, 751–755. [Google Scholar] [CrossRef]
- Singh, H.; Bhardwaj, N.; Arya, S.K.; Khatri, M. Environmental impacts of oil spills and their remediation by magnetic nanomaterials. Environ. Nanotechnol. Monit. Manag. 2020, 100305. [Google Scholar] [CrossRef]
- Liu, B.; Chen, B.; Zhang, B.; Song, X.; Zeng, G.; Lee, K. Photocatalytic ozonation of offshore produced water by TiO2 nanotube arrays coupled with UV-LED irradiation. J. Hazard. Mater. 2020, 402, 123456. [Google Scholar] [CrossRef] [PubMed]
- Cao, Y.; Zhang, B.; Zhu, Z.; Rostami, M.; Dong, G.; Ling, J.; Lee, K.; Greer, C.W.; Chen, B. Access-dispersion-recovery strategy for enhanced mitigation of heavy crude oil pollution using magnetic nanoparticles decorated bacteria. Bioresour. Technol. 2021, 337, 125404. [Google Scholar] [CrossRef]
- Nagamine, M.; Osial, M.; Jackowska, K.; Krysinski, P.; Widera-Kalinowska, J. Tetracycline photocatalytic degradation under CdS treatment. J. Mar. Sci. Eng. 2020, 8, 483. [Google Scholar] [CrossRef]
- Ramutshatsha-Makhwedzha, D.; Ngila, J.C.; Ndungu, P.; Nomngongo, P.N. Ultrasound assisted adsorptive removal of Cr, Cu, Al, Ba, Zn, Ni, Mn, Co and Ti from seawater using Fe2O3-SiO2-PAN nanocomposite: Equilibrium kinetics. J. Mar. Sci. Eng. 2019, 7, 133. [Google Scholar] [CrossRef] [Green Version]
- Lee, S.; You, K.H.; Park, C.B. Highly photoactive, low bandgap TiO2 nanoparticles wrapped by graphene. Adv. Mater. 2012, 24, 1084–1088. [Google Scholar] [CrossRef]
- Goei, R.; Lim, T.-T. Ag-decorated TiO2 photocatalytic membrane with hierarchical architecture: Photocatalytic and anti-bacterial activities. Water Res. 2014, 59, 207–218. [Google Scholar] [CrossRef]
- Fonseca-Cervantes, O.R.; Pérez-Larios, A.; Arellano, V.H.R.; Sulbaran-Rangel, B.; González, C.A.G. Effects in band gap for photocatalysis in TiO2 support by adding gold and ruthenium. Processes 2020, 8, 1032. [Google Scholar] [CrossRef]
- Banerjee, S.; Gopal, J.; Muraleedharan, P.; Tyagi, A.K.; Raj, B. Physics and chemistry of photocatalytic titanium dioxide: Visualization of bactericidal activity using atomic force microscopy. Curr. Sci. 2006, 90, 1378–1383. [Google Scholar]
- de Dicastillo, C.L.; Correa, M.G.; Martínez, F.B.; Streitt, C.; Galotto, M.J. Antimicrobial effect of titanium dioxide nanoparticles. IntechOpen 2021. Available online: https://www.intechopen.com/books/antimicrobial-resistance-a-one-health-perspective/antimicrobial-effect-of-titanium-dioxide-nanoparticles (accessed on 26 August 2021). [CrossRef] [Green Version]
- Furlan, P.Y.; Furlan, A.Y.; Kisslinger, K.; Melcer, M.E.; Shinn, D.W.; Warren, J.B. Water as the solvent in the stober process for forming ultrafine silica shells on magnetite nanoparticles. ACS Sustain. Chem. Eng. 2019, 7, 15578–15584. [Google Scholar] [CrossRef]
- Alvarez, P.; Jaramillo, J.; López-Piñero, F.; Plucinski, P.K. Preparation and characterization of magnetic TiO2 nanoparticles and their utilization for the degradation of emerging pollutants in water. Appl. Catal. B Environ. 2010, 100, 338–345. [Google Scholar] [CrossRef]
- Pang, S.C.; Kho, S.Y.; Chin, S.F. Fabrication of Magnetite/Silica/Titania Core-Shell Nanoparticles. J. Nanomater. 2012, 2012, 1–6. [Google Scholar] [CrossRef] [Green Version]
- Wang, R.; Wang, X.; Xi, X.; Hu, R.; Jiang, G. Preparation and photocatalytic activity of magnetic Fe3O4/SiO2/TiO2 Composites. Adv. Mater. Sci. Eng. 2012, 2012, 1–8. [Google Scholar] [CrossRef] [Green Version]
- Rashid, J.; Barakat, M.A.; Ruzmanova, Y.; Chianese, A. Fe3O4/SiO2/TiO2 nanoparticles for photocatalytic degradation of 2-chlorophenol in simulated wastewater. Environ. Sci. Pollut. Res. 2014, 22, 3149–3157. [Google Scholar] [CrossRef]
- Kunarti, E.; Syoufian, A.; Budi, I.; Pradipta, A. Preparation and properties of Fe3O4/SiO2/TiO2 core-shell nanocomposite as recoverable photocatalyst. Asian J. Chem. 2016, 28, 1343–1346. [Google Scholar] [CrossRef]
- Mortazavi-Derazkola, S.; Salavati-Niasari, M.; Amiri, O.; Abbasi, A. Fabrication and characterization of Fe3O4@SiO2@TiO2@Ho nanostructures as a novel and highly efficient photocatalyst for degradation of organic pollution. J. Energy Chem. 2017, 26, 17–23. [Google Scholar] [CrossRef] [Green Version]
- Shahid, M.; McDonagh, A.; Kim, J.H.; Shon, H.K. Magnetised titanium dioxide (TiO2) for water purification: Preparation, characterisation and application. Desalination Water Treat. 2014, 54, 979–1002. [Google Scholar] [CrossRef] [Green Version]
- Magaña-López, R.; Zaragoza-Sánchez, P.; Jiménez-Cisneros, B.; Chávez-Mejía, A. The use of TiO2 as a disinfectant in water sanitation applications. Water 2021, 13, 1641. [Google Scholar] [CrossRef]
- Simonsen, M.E.; Søgaard, E.G. Sol–gel reactions of titanium alkoxides and water: Influence of pH and alkoxy group on cluster formation and properties of the resulting products. J. Sol-Gel Sci. Technol. 2010, 53, 485–497. [Google Scholar] [CrossRef] [Green Version]
- Kalska-Szostko, B.; Wykowska, U.; Satuła, D.; Nordblad, P. Thermal treatment of magnetite nanoparticles. Beilstein J. Nanotechnol. 2015, 6, 1385–1396. [Google Scholar] [CrossRef] [PubMed] [Green Version]
- Topal, U.; Aksan, M.A. Phase stabilization of magnetite (Fe3O4) nanoparticles with B2O3 addition: A significant enhancement on the phase transition temperature. J. Magn. Magn. Mater. 2016, 406, 123–128. [Google Scholar] [CrossRef]
- Ruff. Anatase X-ray Diffraction Pattern Computed Using Published Structural Information. Available online: https://rruff.info/anatase/display=default/R060277 (accessed on 26 August 2021).
- Ruff. Rutile X-ray Diffraction Pattern Computed Using Published Structural Information. Available online: https://rruff.info/rutile/display=default/R040049 (accessed on 26 August 2021).
- Ruff. Magnetite X-ray Diffraction Pattern Computed Using Published Structural Information. Available online: https://rruff.info/magnetite/display=default/R061111 (accessed on 26 August 2021).
- Ruff. Hematite X-ray Diffraction Pattern Computed Using Published Structural Information. Available online: https://rruff.info/hematite/display=default/R110013 (accessed on 26 August 2021).
- He, J.; Du, Y.-E.; Bai, Y.; An, J.; Cai, X.; Chen, Y.; Wang, P.; Yang, X.; Feng, Q. Facile formation of anatase/rutile TiO2 nanocomposites with enhanced photocatalytic activity. Molecules 2019, 24, 2996. [Google Scholar] [CrossRef] [Green Version]
- Soler-Illia, G.; Louis, A.; Sanchez, C. Synthesis and characterization of mesostructured titania-based materials through evaporation-induced self-assembly. Chem. Mater. 2002, 14, 750–759. [Google Scholar] [CrossRef]
- Zeitler, V.A.; Brown, C.A. The infrared spectra of some Ti-O-Si, Ti-O-Ti and Si-O-Si compounds. J. Phys. Chem. 1957, 61, 1174–1177. [Google Scholar] [CrossRef]
- Cuenca, J.A.; Bugler, K.; Taylor, S.; Morgan, D.; Williams, P.; Bauer, J.; Porch, A. Study of the magnetite to maghemite transition using microwave permittivity and permeability measurements. J. Phys. Condens. Matter 2016, 28, 106002. [Google Scholar] [CrossRef] [PubMed] [Green Version]
- Simon-Deckers, A.; Loo, S.; Mayne-L’hermite, M.; Herlin-Boime, N.; Menguy, N.; Reynaud, C.; Gouget, B.; Carriere, M. Size-, composition- and shape-dependent toxicological impact of metal oxide nanoparticles and carbon nanotubes toward bacteria. Environ. Sci. Technol. 2009, 43, 8423–8429. [Google Scholar] [CrossRef]
- Rickerby, D.G. Nanostructured titanium dioxide for photocatalytic water treatment. Nanomater. Environ. Prot. 2014, 2014, 169–182. [Google Scholar] [CrossRef]
- Save the Sound. Long Island Sound Report Card. Available online: https://www.savethesound.org/report-card (accessed on 26 August 2021).
- Coohill, T.P.; Sagripanti, J.-L. Bacterial inactivation by solar ultraviolet radiation compared with sensitivity to 254 nm radiation. Photochem. Photobiol. 2009, 85, 1043–1052. [Google Scholar] [CrossRef] [PubMed]
- Nelson, K.L.; Boehm, A.B.; Davies-Colley, R.J.; Dodd, M.C.; Kohn, T.; Linden, K.G.; Liu, Y.; Maraccini, P.A.; McNeill, K.; Mitch, W.A.; et al. Sunlight-mediated inactivation of health-relevant microorganisms in water: A review of mechanisms and modeling approaches. Environ. Sci. Process. Impacts 2018, 20, 1089–1122. [Google Scholar] [CrossRef] [PubMed]
- Hoerter, J.D.; Arnold, A.A.; Kuczynska, D.A.; Shibuya, A.; Ward, C.; Sauer, M.G.; Gizachew, A.; Hotchkiss, T.M.; Fleming, T.J.; Johnson, S. Effects of sublethal UVA irradiation on activity levels of oxidative defense enzymes and protein oxidation in Escherichia coli. J. Photochem. Photobiol. B 2005, 81, 171–180. [Google Scholar] [CrossRef]

| Element | MS-TO2-3 | MS-TO2-7 | MS-TO2-10 |
|---|---|---|---|
| Fe | 50.2 | 31.5 | 42.0 |
| O | 42.1 | 58.3 | 40.7 |
| Si | 5.3 | 4.6 | 4.8 |
| Ti | 2.5 | 5.6 | 12.6 |
| As-prepared | Annealed at 300 °C | |||
|---|---|---|---|---|
| MIT98, min | % Reduction at 70 min | MIT98, min | % Reduction at 70 min | |
| Control (blank) | 50 ± 5 | >98 | 50 ± 5 | >98 |
| MS-TiO2-3 (2.5% Ti) | >70 | 80 ± 5 | 25 ± 5 | >98 |
| MS-TiO2-7 (5.6% Ti) | >70 | 75 ± 5 | 65 ± 5 | >98 |
| MS-TiO2-10 (12.6% Ti) | >70 | 86 ± 5 | 25 ± 5 | >98 |
| Trial | MIT98, min | |||
|---|---|---|---|---|
| Control | 30 mg | 10 mg | 1 mg | |
| 1 | 90 | 100 | 80 | 90 |
| 2 | 110 | 110 | 70 | 90 |
| 3 | 90 | 120 | 90 | 100 |
| Average | 97 ± 9 | 110 ± 8 | 80 ± 8 | 93 ± 8 |
Publisher’s Note: MDPI stays neutral with regard to jurisdictional claims in published maps and institutional affiliations. |
© 2021 by the authors. Licensee MDPI, Basel, Switzerland. This article is an open access article distributed under the terms and conditions of the Creative Commons Attribution (CC BY) license (https://creativecommons.org/licenses/by/4.0/).
Share and Cite
Keeley, M.; Kisslinger, K.; Adamson, C.; Furlan, P.Y. Magnetically Recoverable and Reusable Titanium Dioxide Nanocomposite for Water Disinfection. J. Mar. Sci. Eng. 2021, 9, 943. https://doi.org/10.3390/jmse9090943
Keeley M, Kisslinger K, Adamson C, Furlan PY. Magnetically Recoverable and Reusable Titanium Dioxide Nanocomposite for Water Disinfection. Journal of Marine Science and Engineering. 2021; 9(9):943. https://doi.org/10.3390/jmse9090943
Chicago/Turabian StyleKeeley, Monica, Kim Kisslinger, Carman Adamson, and Ping Y. Furlan. 2021. "Magnetically Recoverable and Reusable Titanium Dioxide Nanocomposite for Water Disinfection" Journal of Marine Science and Engineering 9, no. 9: 943. https://doi.org/10.3390/jmse9090943
APA StyleKeeley, M., Kisslinger, K., Adamson, C., & Furlan, P. Y. (2021). Magnetically Recoverable and Reusable Titanium Dioxide Nanocomposite for Water Disinfection. Journal of Marine Science and Engineering, 9(9), 943. https://doi.org/10.3390/jmse9090943






